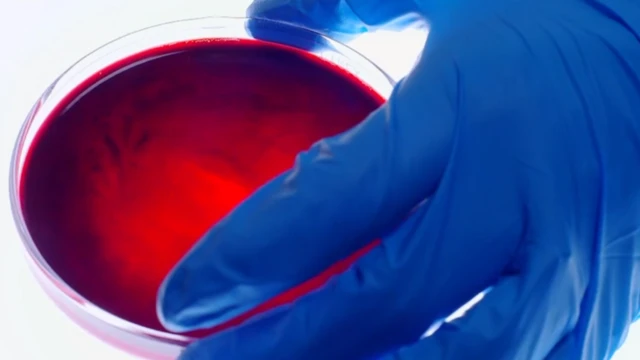
Sangre mezclada con hemotoxina.

La extraordinaria historia del hombre que se inyecta veneno letal de serpiente pero no se muere

- Autor, Redacción
- Título del autor, BBC Mundo
"Me he pasado toda la vida leyendo sobre las serpientes, buscándolas... empecé a tenerlas como mascotas cuando tenía 6 años", le cuenta Steve Ludwin a la BBC.
"Mi padre me llevó al serpentario de Miami y allí vi a Bill Haast, el primer occidental que empezó a inyectarse veneno de serpiente", continúa.
Haast era un entusiasta de las serpientes que creía que el veneno de estos animales tiene propiedades curativas y por eso se lo inyectaba en la sangre.
"Siendo niño la idea me impactó mucho. Dije ¡guau! y me quedé con esa historia", recuerda.

"Y cuando tenía 17 años tuve un momento en que se me iluminó la bombilla y decidí hacer lo mismo que él. Voy a copiarlo", recuerda.
Hoy, Steve lleva casi 30 años inyectándose veneno.
Una colección en casa
Steve tiene su propia colección de serpientes, de las que extrae regularmente su veneno sujetando cuidadosamente la cabeza de los reptiles mientras estos muerden un vaso cubierto con un plástico transparente.
"Es muy doloroso y no le causa dolor a las serpientes", describe Steve.
El veneno particular que extrajo frente a las cámaras de la BBC es una hemotoxina, afecta a la sangre.

Estas toxinas destruyen los glóbulos rojos de la sangre y pueden causar daños generalizados en los tejidos y en los órganos.
Las heridas por una sustancia hemotóxica suelen ser dolorosas e incluso cuando se aplica un tratamiento inmediato las personas que las sufren pueden tener daños permanentes o sufrir la amputación del miembro afectado.
También puede ser fatal.
Pero Steve, se inyecta a sí mismo un poco de ese veneno.

Primero Steve se pone el veneno sobre la piel y después utiliza una aguja para romper la piel e introducirlo en su cuerpo.
"No es una sensación agradable. Inmediatamente sientes una quemazón", describe.

Según la doctora Gabriel Weston, presentadora de la serie de televisión de la BBC "Incredible Medicine: Dr. Weston's casebook", Steve tiene suerte de estar vivo.

Lee otras impresionantes historias del programa de la BBC "Incredible Medicine: Dr Weston's casebook":
- La mujer a la que le crecen huesos sobre los huesos
- El joven que vivió dos meses encerrado en su propio cuerpo y pudo salir para contarlo
- El secreto de la capacidad extraordinaria del hombre que corrió 50 maratones en 50 días
- La extraordinaria historia de los padres que inventaron una medicina para salvar la vida de sus hijas

¿Qué le pasa al cuerpo?
Utilizando una muestra de su propia sangre, la doctora Weston expone en el programa de televisión qué pasa cuando se mezcla con la hemotoxina.
El líquido se oscurece en cuestión de segundos y empieza a coagularse "como un gel" en algunos puntos.
"Si esta sangre estuviera fluyendo por tu arterias, esencialmente se detendría. Y por eso te mueres", explica.
"Hasta un coágulo pequeño podría ser fatal", dice Weston.
Pero entonces, ¿cómo es que Steve sobrevive al veneno más letal?
Como si estuviera vacunado
"Mi sangre es única porque llevo casi 30 años haciendo esto", dice el entusiasta de las serpientes.
La exposición gradual de Steve al veneno de serpiente ha funcionado de la misma manera que las vacunas funcionan para la mayoría de nosotros, explica la doctora Weston.

Las vacunas nos dan una dosis baja de un virus o una toxina: no la cantidad suficiente como para hacernos daño pero sí como para que nuestros cuerpos puedan aprender a combatirla y así protegernos para el futuro.
Nuestros sistema inmunológico hace esto generando unas células de defensa especializadas llamadas anticuerpos. Cada tipo de anticuerpo tiene una forma única para atacar a un virus o toxina particular.
Cuando Steve se embarcó en estos experimentos empezó con dosis extremadamente pequeñas.
Así que su cuerpo aprendió a reconocer diferentes venenos y a producir anticuerpos específicos para luchar contra cada uno de ellos, explica Weston.

"Mi cuerpo reacciona de una manera diferente", dice Steve
"No se inflama tanto y cuando lo hace se recupera mucho más rápido".
"Puedo morir con una sonrisa"
El peligroso hábito de Steve empezó como una suerte de desafío personal. Pero recientemente captó la atención de un equipo de científicos de la Universidad de Copenhague, en Dinamarca.
Los ingenieros farmacéuticos Andreas Hougaard Laustseny y Brian Lohse llevan un tiempo tratando de desarrollar un antídoto para las picaduras de serpientes.
"Las picaduras de serpientes son un problema mucho más grande de lo que mucha gente cree. Se considera el más desatendido de todos los problemas de salud tropical desatendidos", le dijo Andreas a la BBC.
"Se estima que cada año en el África subsahariana ocurren un millón de picaduras de serpiente venenosa, y que probablemente entre 50.000 y 100.000 personas mueren cada año por culpa de estas picaduras", añade.

Si te pica una serpiente venenosa el único tratamiento disponible es una dosis de anticuerpos administrada a través de un medicamento llamado antivenom o antisuero. Pero actualmente hay una escasez global de este tratamiento.
Además, "el antisuero que existe está hecho con anticuerpos de sangre de caballo, así que conlleva riesgos para su uso en humanos", explica la doctora Weston.
En efecto, su aplicación puede tener efectos adversos: "En los peores casos la administración del antisuero puede llegar a producir la muerte del paciente, no por la picadura de la serpiente sino por el antisuero", explica Hougaard Laustseny.
Por eso los científicos están trabajando ahora en la producción de un antisuero seguro para el hombre, hecho a partir de anticuerpos de sangre humana.
Pensaron que lograr esto en el laboratorio tomaría diez años, hasta que conocieron el caso de Steve. En él tenían "la fuente de los anticuerpos que necesitaban", dice Weston.
Ahora este equipo de científicos daneses está trabajando con su sangre, para recolectar sus anticuerpos y replicarlos a una escala masiva. "Ahora puedo morir con una sonrisa porque he conseguido hacer algo positivo y eso me hace sentir muy bien", dijo Steve.









